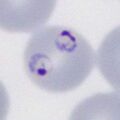
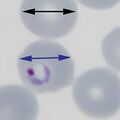
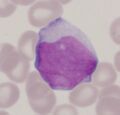
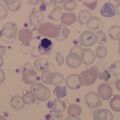
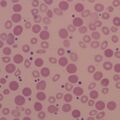
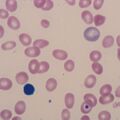
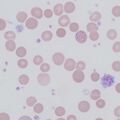
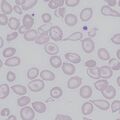

Uncategorised files
Showing below up to 50 results in range #1 to #50.
- 11double3.jpg 472 × 472; 28 KB
- 11multiple1.jpg 472 × 472; 30 KB
- 11multiple2.jpg 472 × 472; 37 KB
- 11multiple3.jpg 472 × 472; 40 KB
- 11multiple4.jpg 472 × 472; 40 KB
- 1SizePMET.jpg 472 × 472; 81 KB
- 2SizePMLT.jpg 472 × 472; 64 KB
- 3SizePMET.jpg 472 × 472; 50 KB
- 4SizePFLT.jpg 472 × 472; 47 KB
- 5SizePOET.jpg 472 × 472; 69 KB
- 6SizePOLT.jpg 472 × 472; 55 KB
- 7SizePVET.jpg 472 × 472; 55 KB
- 8SizePVLT.jpg 593 × 591; 93 KB
- AC1.png 472 × 472; 53 KB
- AC2.png 472 × 472; 184 KB
- AMLM5A.jpg 299 × 287; 31 KB
- AMLM5B.jpg 300 × 296; 32 KB
- AML M1.png 472 × 472; 174 KB
- AML M2.png 472 × 472; 146 KB
- Ac3.jpg 472 × 472; 48 KB
- Ac4.jpg 472 × 472; 63 KB
- Ac5.jpg 472 × 472; 46 KB
- Ac6.jpg 472 × 472; 56 KB
- Agglutination1.jpg 591 × 591; 70 KB
- Agglutination2.jpg 591 × 591; 53 KB
- Agglutination3.jpg 472 × 472; 80 KB
- Amoeboid1.jpg 472 × 472; 28 KB
- Amoeboid2.jpg 472 × 472; 29 KB
- Aniso0.png 472 × 472; 135 KB
- AnisoC0.png 472 × 472; 124 KB
- Anisochromia 1.jpg 1,417 × 1,419; 332 KB
- Anisochromia 2.jpg 591 × 591; 91 KB
- Anisocytosis 1.jpg 594 × 593; 56 KB
- Anisocytosis 2.jpg 591 × 590; 54 KB
- BS0.png 472 × 472; 88 KB
- BS0A.png 496 × 496; 83 KB
- BS1.png 472 × 472; 96 KB
- BS1A.png 472 × 472; 121 KB
- BS2.jpg 472 × 472; 27 KB
- BS3.jpg 472 × 472; 74 KB
- BS4.jpg 472 × 472; 90 KB
- BS5.jpg 472 × 472; 33 KB
- BS6.jpg 472 × 472; 42 KB
- BabRing1.jpg 472 × 472; 97 KB
- BabRing2.jpg 472 × 472; 88 KB
- BabRing3.jpg 472 × 472; 28 KB
- Biology.jpg 472 × 472; 40 KB
- Blood stages schizonts only.jpg 472 × 472; 77 KB
- Boat0.png 472 × 472; 60 KB
- Boat1.png 472 × 472; 60 KB